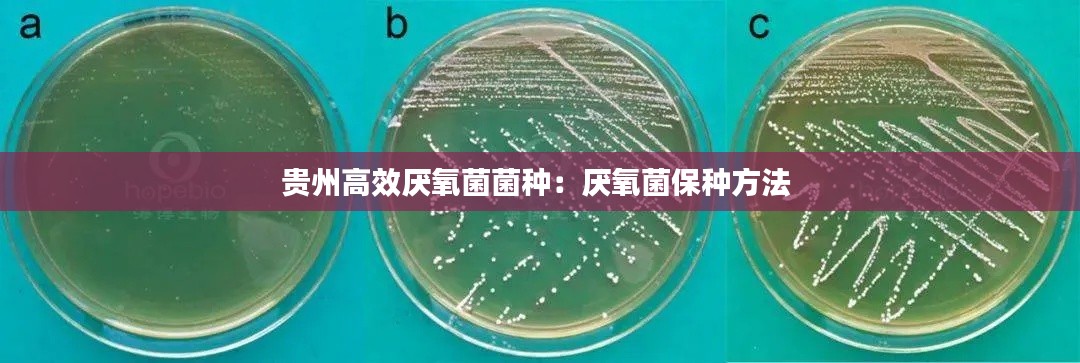

今日生肖运势解析,穿衣指南助你把握好运!
随着人们对传统文化的重视,生肖运势成为了越来越多人关注的焦点,在现代快节奏的生活中,我们不仅关注自己的健康和工作,也开始关心每日的生肖运势,今天我们就来谈谈如何通过穿衣搭配来迎接好运,以及如何查询最新的生肖穿衣运势。...
世界忠诚僚机排行榜TOP,谁是最强忠诚伙伴?
在航空领域,僚机的重要性不言而喻,而在众多僚机中,哪些能够跻身世界最强忠诚僚机的行列呢?本文将为您揭示世界最强忠诚僚机排名,带您领略这些忠诚伙伴的风采。F-16战斗鹰的忠诚僚机F-16战斗鹰作为一款经典的战斗机,在全...
充电宝电芯设计规范:充电宝电芯电压正常是多少
引言随着便携式电子设备的普及,充电宝成为了日常生活中不可或缺的配件。充电宝的电芯设计直接影响到其续航能力、安全性以及使用寿命。本文将详细介绍充电宝电芯的设计规范,以帮助读者更好地了解这一领域。电芯类型选择充电宝...
全新饺子店开业,美食盛宴不容错过!
我们诚挚地邀请您参与一场美食盛宴,共同见证全新饺子店的开业盛典!我们用心打造了一个充满温馨与美味的饺子世界,为您带来前所未有的味蕾享受。传承与创新,饺子的魅力无限延伸我们的饺子店秉承传统制作工艺,结合现代创新理念,致...
恩施建筑裂缝修补规范:建筑裂缝相关法律法规
引言恩施建筑裂缝修补规范是一套旨在确保建筑结构安全、稳定和耐久性的技术标准。随着城市化进程的加快和建筑物的老化,裂缝问题在建筑中日益普遍。为了提高建筑物的使用寿命和居住安全,制定一套科学的裂缝修补规范显得尤为重要。...
信息遥感期刊排名TOP10,权威榜单揭晓!
随着科技的飞速发展,信息遥感技术已成为当今世界的热门话题,该技术以其独特的优势,广泛应用于环境监测、城市规划、农业管理等诸多领域,在学术界,信息遥感期刊更是研究者们争相投稿的重要平台,本文将为您介绍信息遥感期刊排名前...
翼博 点烟器不断电:翼虎点烟器不断电
翼博汽车简介翼博汽车,作为一款紧凑型SUV,自上市以来就凭借其时尚的外观、宽敞的空间和丰富的配置受到了消费者的喜爱。在众多汽车品牌中,翼博以其独特的魅力脱颖而出,成为市场上的一股清新力量。点烟器不断电功能的重要性...
贵州高效厌氧菌菌种:厌氧菌保种方法
引言厌氧菌在生物处理领域扮演着至关重要的角色,尤其是在有机废水处理中。贵州作为中国西南地区的重要省份,拥有丰富的生物资源。近年来,贵州高效厌氧菌菌种的研究取得了显著进展,为当地乃至全国的废水处理提供了新的技术支持。...
乡镇突发杀人案:乡镇命案防控表态发言材料
案件发生背景位于我国某省的一个宁静小镇,一直以来都以和谐、安宁著称。然而,在这个看似平静的表面之下,一场突如其来的悲剧正在酝酿。2023年3月15日,这个小镇发生了一起令人震惊的杀人案,打破了小镇的宁静。案件经过...
翻译工作热门领域,翻译行业
引言随着全球化进程的不断加速,翻译工作的重要性日益凸显。翻译不仅是语言之间的桥梁,更是文化交流和商业合作的纽带。在众多翻译领域中,有些领域因其独特的市场需求和挑战性而成为了热门选择。本文将探讨几个当前翻译工作热门领...

蜀ICP备2020032544号-3